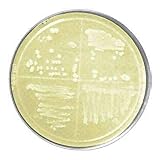

All Categories


Ricca 2330-32 Copper Sulfate, 1.053 Specific Gravity, for Hemoglobin Estimation in Blood Donor Screening of Men and Women, 1 L
Share Tweet
*Price and Stocks may change without prior notice
*Packaging of actual item may differ from photo shown
- Electrical items MAY be 110 volts.
- 7 Day Return Policy
- All products are genuine and original
- Cash On Delivery/Cash Upon Pickup Available








Ricca 2330-32 Copper Sulfate, 1.053 Specific Features
-
For In Vitro Diagnostic Use
-
Ready-to-use solutions provide savings in raw materials, labor and waste disposal
-
Tight specifications for the most accurate results
-
Minimal lot-to-lot variation improves reproducibility
-
Certified traceable to NIST for regulatory compliance
About Ricca 2330-32 Copper Sulfate, 1.053 Specific
Ricca Chemical Company 2330-32 Copper Sulfate, 1.053 Specific Gravity, 1 L is for In Vitro Diagnostic Use and is suitable for use in Hemoglobin Estimation in Blood Donor Screening of Men and Women. The specification on Copper Sulfate, 1.053 Specific Gravity is 1.0531 plus-or-minus 0.0001 sp gr at 25 degrees Celsius. This solution is lot numbered and expiration dated.